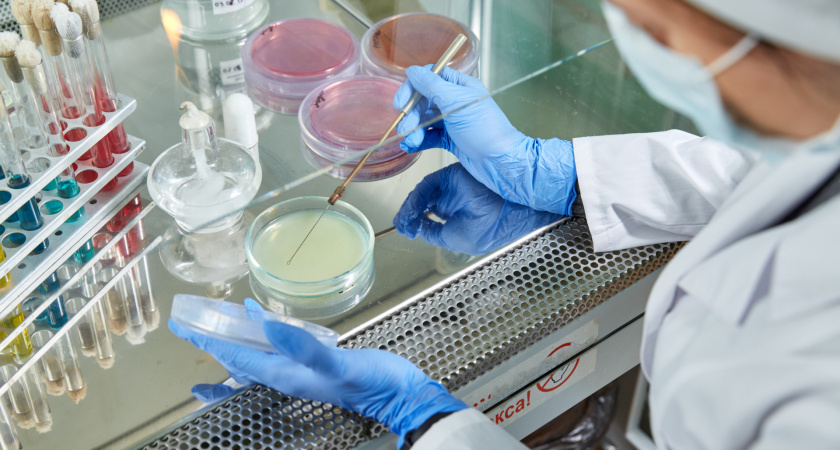

Тверские сметана и творог с кишечной палочкой: проверка вскрыла санитарный кошмар
- 19 июля 2025
- Артем Путинцев
Россельхознадзор готовится ввести санкции против недобросовестных производителей молочной продукции в Тверской области. Поводом стали тревожные результаты экспертизы Тверской испытательной лаборатории (ФГБУ «ВНИИЗЖ»), подтвердившие наличие бактерий кишечной палочки в четырех видах продукции: сметане 20% жирности, твороге 9% жирности, ряженке 3,2% жирности и сыре «Российский» 50% жирности.
Исследования, проведенные 16 июля, четко указали на причину – неудовлетворительное санитарное состояние производственных цехов. Специалисты лаборатории связывают это с типичными нарушениями: отсутствием должной дезинфекции инвентаря, загрязненными производственными линиями или игнорированием персоналом элементарных правил гигиены.
Полученные данные незамедлительно внесены в федеральные системы мониторинга «Веста» и «Сирано» для предотвращения оборота опасных товаров.
Управление Россельхознадзора по Тверской и Ярославской областям, куда направлены все документы по проверке, инициирует внеплановые выездные проверки на выявленных предприятиях-нарушителях. Если нарушения подтвердятся, опасная продукция будет изъята из магазинов, а сами производители понесут административную ответственность в виде крупных штрафов.
Ранее сообщалось, что специалисты Тверской лаборатории забраковали 3 тонны ярославского сливочного масла. В ходе проверки непосредственно на предприятии-изготовителе в продукции нашли запрещенную ГОСТом кишечную палочку (колиформу), а также трехкратное превышение допустимого числа микробов.